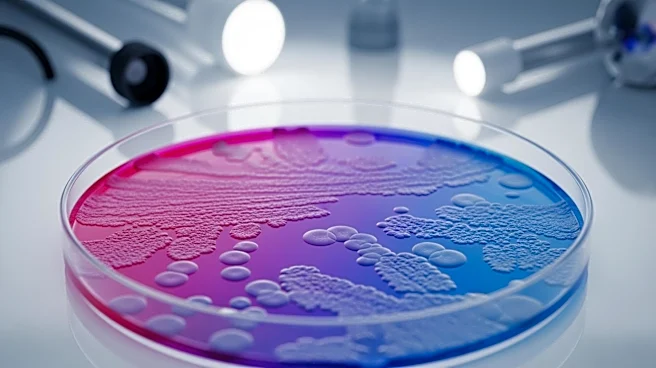

What's Happening?
A study by University College London suggests that gut microbiome analysis can reveal an elevated risk of Parkinson's disease years before symptoms appear. Researchers found that individuals with Parkinson's have a distinctive gut microbiome composition.
The study also indicates that a balanced diet may reduce the risk of developing a high-risk gut microbiome. The research involved 271 Parkinson's patients, 43 gene carriers with no symptoms, and 150 healthy participants. Findings showed significant microbial differences between Parkinson's patients and healthy individuals, with similar patterns observed in gene carriers.
Why It's Important?
This research highlights the potential of gut microbiome analysis as an early detection tool for Parkinson's disease, offering a non-invasive method to identify individuals at risk before symptoms develop. Early detection could lead to timely interventions, potentially slowing disease progression and improving patient outcomes. The study also underscores the importance of diet in maintaining a healthy gut microbiome, which could influence public health recommendations and dietary guidelines aimed at reducing Parkinson's risk.
What's Next?
Further long-term studies are needed to confirm the reliability of gut microbiome changes as predictors of Parkinson's disease. Researchers may explore interventions, such as dietary modifications or probiotics, to alter the gut microbiome and reduce disease risk. This research could pave the way for new preventive strategies and treatments, potentially transforming the management of Parkinson's disease.